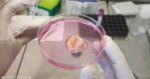

وقالت المصادر، لوكالة الأنباء الألمانية (د ب أ)، إن القوات الإسرائيلية اعتقلت 4 شبان من مدينة قلقيلية بعد اقتحام منازلهم وتفتيشها، كما اعتقلت 4 آخرين من بلدة كفر راعي جنوب جنين بينهم شقيقان، عقب عملية ميدانية شملت استجواب عشرات السكان داخل منازلهم.
وأضافت المصادر أن القوات الإسرائيلية حولت أحد المنازل في البلدة إلى موقع عسكري مؤقت خلال ساعات الاقتحام.
وفي مدينة نابلس، اعتقلت القوات الإسرائيلية مواطنين اثنين أحدهما من منطقة رفيديا بعد تفتيش منزله ومصادرة مركبته، فيما اعتقل الآخر من مخيم عسكر القديم شرقي المدينة.
كما داهمت القوات قريتي عزموط ودير الحطب شرق نابلس وفتشت عددا من المنازل دون الإبلاغ عن اعتقالات إضافية.
وفي محافظة بيت لحم، أفادت المصادر باعتقال شابين من أحياء مختلفة في المدينة عقب اقتحام مناطق شارع الجبل والكركفة، في حين نفذت القوات مداهمات في مخيمي عايدة والعزة شمال المدينة، وعبثت بمحتويات منازل عدة.
كما اعتقلت القوات الإسرائيلية شابا من قرية الجفتلك شمال أريحا بعد اقتحام منزله وتفتيشه، وأفاد شهود عيان بأن الجنود ألحقوا أضرارا بمحتويات المنزل.
وفي محافظة الخليل جنوب الضفة، اعتقلت القوات الإسرائيلية ثلاثة أطفال تتراوح أعمارهم بين 15 و16 عاما من بلدة بيت أمر، عقب اقتحام منازل ذويهم واحتجاز أفراد العائلة في غرف منفصلة لساعات طويلة.
وتأتي هذه الاعتقالات في إطار حملة شبه يومية ينفذها الجيش الإسرائيلي في مدن وبلدات الضفة الغربية، تقول إسرائيل إنها تستهدف “مطلوبين أمنيين”، فيما تعتبرها السلطات الفلسطينية جزءا من سياسة تصعيدية تهدف إلى تقويض الأوضاع الأمنية والضغط على السكان في ظل استمرار التوتر الميداني في الأراضي الفلسطينية.